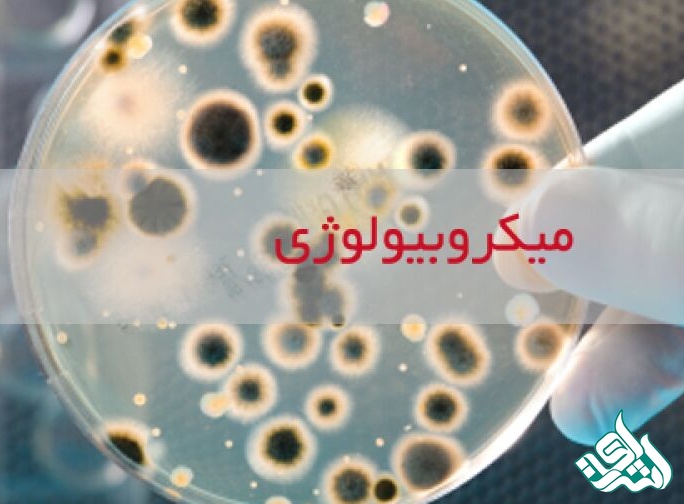

موسسه انتشاراتی اشراق: در این بخش سوالات رشته میکروبیولوژی برای استفاده دانشجویان این رشته به همراه کلید آنها قرار داده شده است.
یکی از راه های آشنایی با سوالات کنکور دکتری، حل تست های کنکور سال های قبل می باشد. شما با حل کردن سوالات کنکور دکترای سال های قبل می توانید ذهن طراح را بخوانید و در ضمن با تله های تستی آشنا شوید. از طرفی میزان استرس شما نیز کم خواهد شد. خواندن سوالان کنکور بخصوص توضیحات تشریحی آنها، کمک می کند تا برخی نکات کلیدی که شاید در طول مطالعه متوجه آنها نشدید را یاد بگیرید و ببینید که کدام بخش های یک درس بیشتر مورد توجه طراحان سوال می باشد. مورد دیگری که باعث تشویق خواندن سوالات کنکور دکتری سال های قبل شده است، این است که در سال های قبل دیده شده که برخی سوالات یا تست ها در دو سال یا چند سال متوالی در کنکور بصورت مشابه و حتی عینا تکرار شده است. در نتیجه با دانستن پاسخ این سوالات شما یک گام نسبت به رقیبان خود جلوتر خواهید بود. با توجه به اینکه در سال های اخیر تیپ سوالات کنکور دکتری به حالت تالیفی درآمده است، پس لازم است حتما در کنار مطالعه دروس تخصصی خود، از سوالات سال های قبل کنکور دکتری نیز استفاده کنید. بنابراین تصمیم گرفتیم تا با قرار دادن سوالات کنکور دکتری از سال 93 تا 97 ( از زمان ادغام شدن کنکور سراسری و آزاد) به دانشجویان و داوطلبان شرکت کننده در کنکور دکتری کمک اندکی کرده باشیم. در این بخش سوالات رشته دکتری میکروبیولوژی برای استفاده دانشجویان این رشته به همراه کلید آنها قرار داده شده است.
سوالات | کلید |
|---|---|
سوالات | سال | کلید |
|---|---|---|
93 | ||
94 | ||
95 | ||
96 | ||
97 |
راههای ارتباطی با موسسه انتشاراتی اشراق
کارشناسان و مشاوران موسسه انتشاراتی اشراق به صورت تماموقت حتی در روزهای تعطیل آماده ارائه خدمات حرفهای و باکیفیت به مشتریان و کاربران خود هستند. برای دریافت مشاوره میتوانید از طریق سایت به صورت آنلاین با مشاورین موسسه گفتوگو کنید و یا از طریق تماس تلفنی با شمارههای زیر در ارتباط باشید:
eshragh_company
isi.eshragh@gmail.com
09149724933
041-33373424